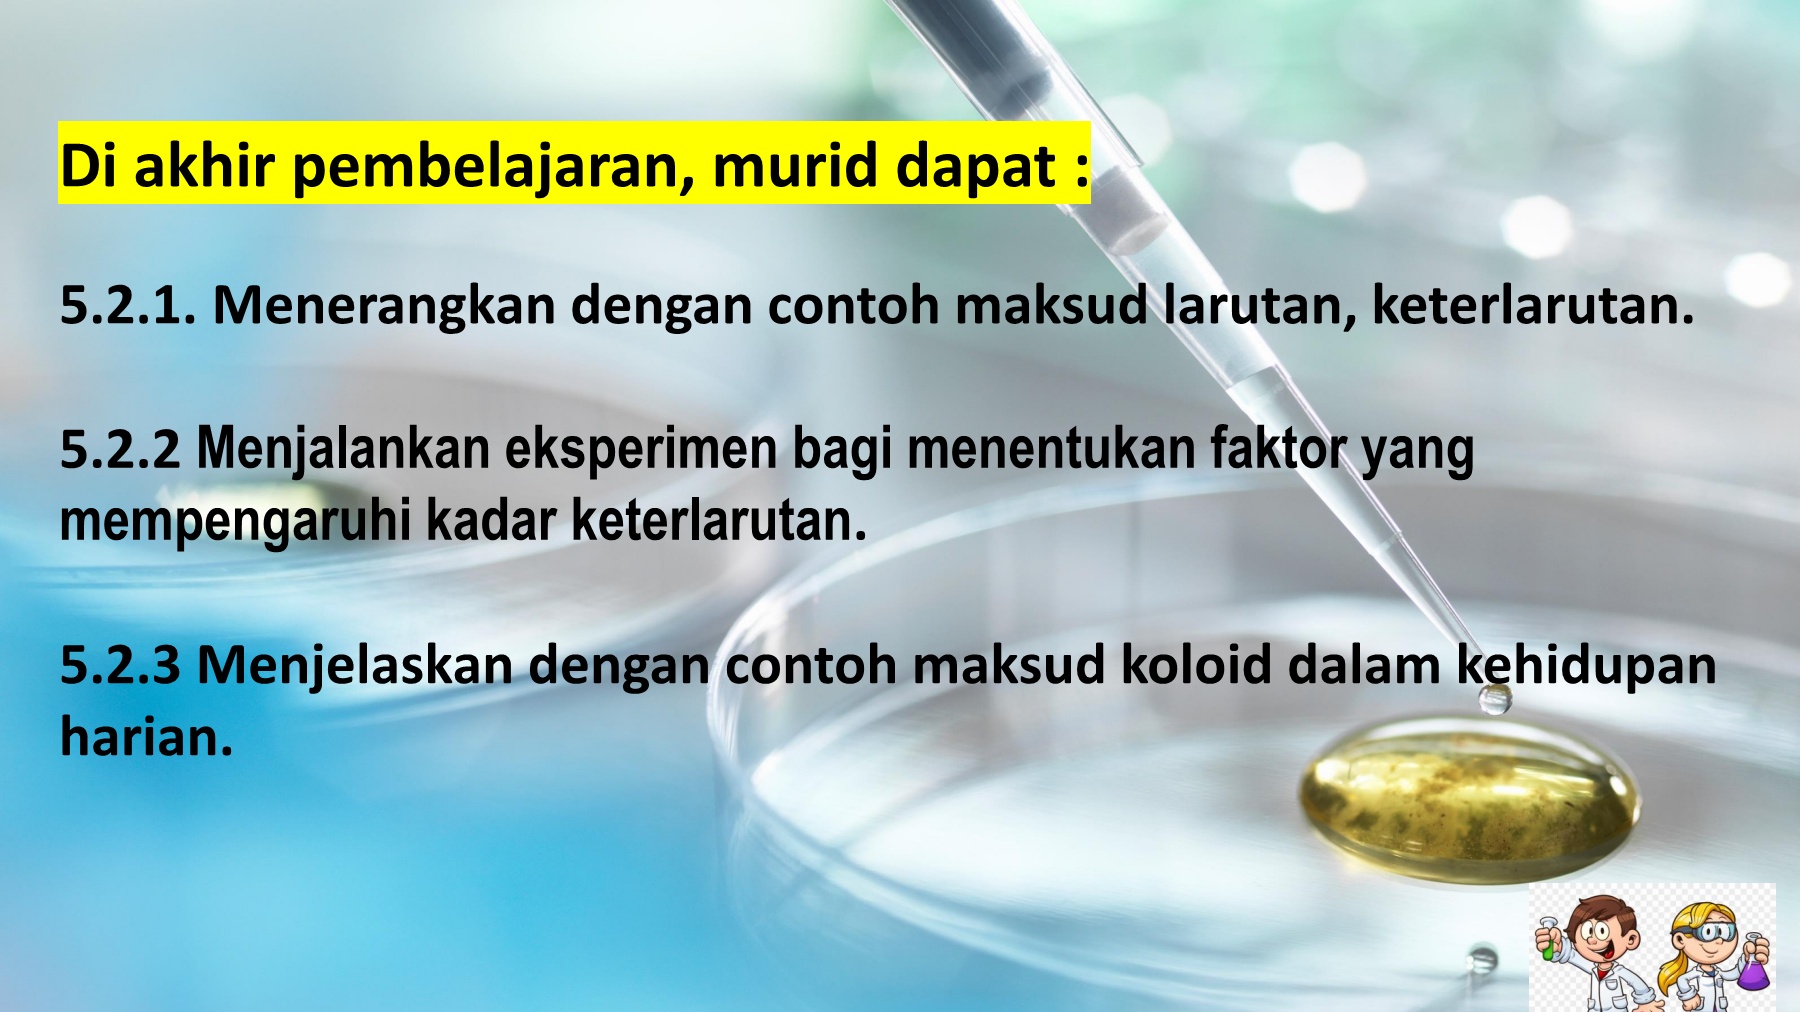
Sc T2 5 2 Larutan Dan Keterlarutan Pp Flip Ebook Pages 1 16 Anyflip Anyflip

Air Sebagai Pelarut Pdf
Zdocs Tips

Eksperimen Faktor Faktor Yang Mempengaruhi Keterlarutan Sains F2


5 4 Larutan Dan Keterlarutan By Nurul Fahimah Jamaludin
5 2 Larutan Dan Kadar Keterlarutan Flip Ebook Pages 1 16 Anyflip Anyflip

Ebelajau Sains Tingkatan 2 Bab 5 5 2 Youtube

Eksperimen Faktor Faktor Yang Mempengaruhi Keterlarutan Sains F2
Sc T2 5 2 Larutan Dan Keterlarutan Pp Flip Ebook Pages 1 16 Anyflip Anyflip

Exp Faktor Pengaruhi Kadar Keterlarutan
Bab 5 2 Larutan Kadar Keterlarutan Spojte Odpovidajici

Snt205 Sains Ting 2 Bab 5 Air Dan Larutan Keterlarutan Dan Kadar Keterlarutan Youtube
Tags:
Archive